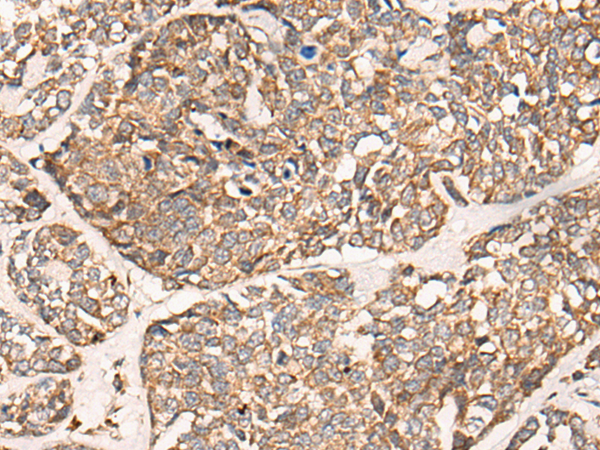

中文名稱: 兔抗DGKI多克隆抗體
|
Background: |
This gene is a member of the type IV diacylglycerol kinase subfamily. Diacylglycerol kinases regulate the intracellular concentration of diacylglycerol through its phosphorylation, producing phosphatidic acid. The specific role of the enzyme encoded by this gene is undetermined, however, it may play a crucial role in the production of phosphatidic acid in the retina or in recessive forms of retinal degeneration. |
|
Applications: |
ELISA, IHC |
|
Name of antibody: |
DGKI |
|
Immunogen: |
Synthetic peptide of human DGKI |
|
Full name: |
diacylglycerol kinase iota |
|
Synonyms: |
DGK-IOTA |
|
SwissProt: |
O75912 |
|
ELISA Recommended dilution: |
5000-10000 |
|
IHC positive control: |
Human esophagus cancer and human lung cancer |
|
IHC Recommend dilution: |
25-100 |

購物車
購物車 幫助
幫助
 021-54845833/15800441009
021-54845833/15800441009
